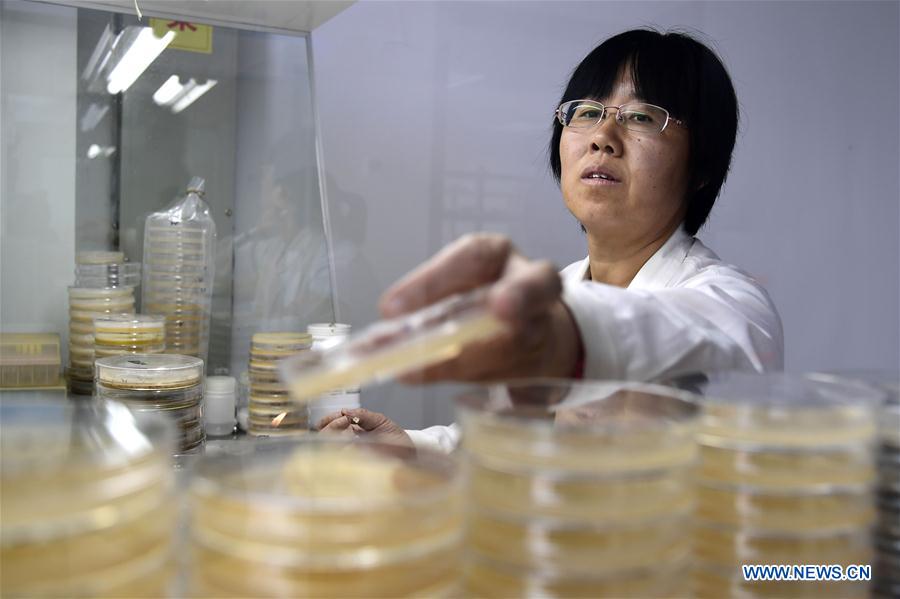
CHINA-SHANDONG-SCO-SCIENTIFIC AND TECHNOLOGICAL COOPERATION (CN)

A technician works at a lab of the Ecology Institute of Shandong Academy of Sciences in Jinan, east China's Shandong Province, May 11, 2018. It is a project to promote ecological restoration and high efficient utilization of salt-affected soils in China and Uzbekistan. Shandong Academy of Sciences strengthened scientific and technological cooperation with member states of the Shanghai Cooperation Organization (SCO) and has established 13 national-level innovation platforms. (Xinhua/Guo Xulei)















